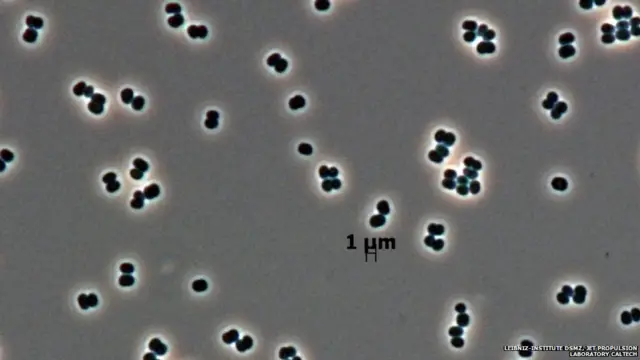
क्लीन रूम माइक्रोबीज़, डीएसएमज़ेड, कैलटेक

साल की दस सर्वश्रेष्ठ प्रजातियाँ
इस साल की दस सर्वश्रेष्ठ प्रजातियाँ पिछले 12 महीनों में खोजी गई हैं. वैज्ञानिकों का अनुमान है कि एक करोड़ प्रजातियाँ ऐसी हैं जिनके बारे में मनुष्य को जानकारी नहीं है. जबकि 20 लाख प्रजातियों के बारे में हम जान चुके हैं.